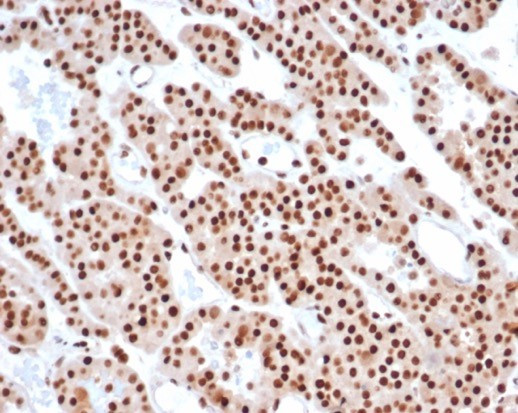
PCNA (Proliferating Cell Nuclear Antigen) (G1- and S-phase Marker) Antibody in Immunohistochemistry (Paraffin) (IHC (P))

Search
NeoBiotechnologies
PCNA (Proliferating Cell Nuclear Antigen) (G1- and S-phase Marker) Monoclonal Antibody (PCNA/6580)
{{$productOrderCtrl.translations['antibody.pdp.commerceCard.promotion.promotions']}}
{{$productOrderCtrl.translations['antibody.pdp.commerceCard.promotion.viewpromo']}}
{{$productOrderCtrl.translations['antibody.pdp.commerceCard.promotion.promocode']}}: {{promo.promoCode}} {{promo.promoTitle}} {{promo.promoDescription}}. {{$productOrderCtrl.translations['antibody.pdp.commerceCard.promotion.learnmore']}}
图: 1 / 6
PCNA (Proliferating Cell Nuclear Antigen) (G1- and S-phase Marker) Antibody (5111-MSM5-P1ABX) in IHC (P)






产品信息
5111-MSM5-P1ABX
种属反应
宿主/亚型
分类
类型
克隆号
抗原
偶联物
形式
浓度
规格
纯化类型
保存液
内含物
保存条件
运输条件
靶标信息
PCNA (polymerase delta auxiliary protein) is essential for DNA replication and is involved in DNA excision and mismatch repair pathways. PCNA binds to the CDK inhibitor p21, the structure-specific endonucleases Fen1 and XPG, and DNA cytosine 5-methyltransferase (MCMT). PCNA is a potentially useful marker of cells with proliferative potential and for identifying the proliferation status of tumor tissue (i.e. relevant to prognosis). PCNA is a marker for cells in early G1 phase and S phase of the cell cycle. PCNA is found in the nucleus and is a cofactor of DNA polymerase delta, and acts as a homotrimer and helps increase the processing of leading strand synthesis during DNA replication. In response to DNA damage, PCNA is ubiquitinated and is involved in the RAD6-dependent DNA repair pathway. Two transcript variants encoding the same protein have been found for PCNA. Pseudogenes of PCNA have been described on chromosome 4 and on the X chromosome.
仅用于科研。不用于诊断过程。未经明确授权不得转售。
篇参考文献 (0)
生物信息学
蛋白别名: Cyclin; DNA polymerase delta auxiliary protein; DNA sliding clamp PCNA; HGCN8729; MGC8367; PCNA; Proliferating cell nuclear antigen; unnamed protein product
基因别名: ATLD2; PCNA
UniProt ID: (Human) P12004
Entrez Gene ID: (Human) 5111